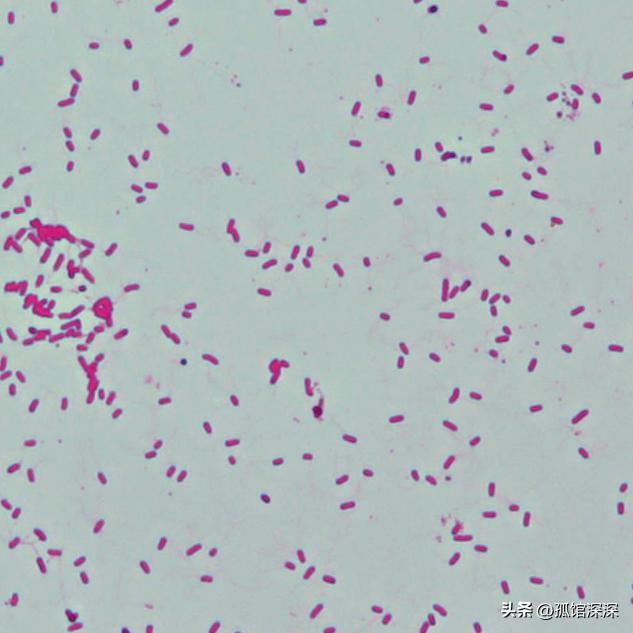
奇异性变形杆菌,奇异变形杆菌内源性感染
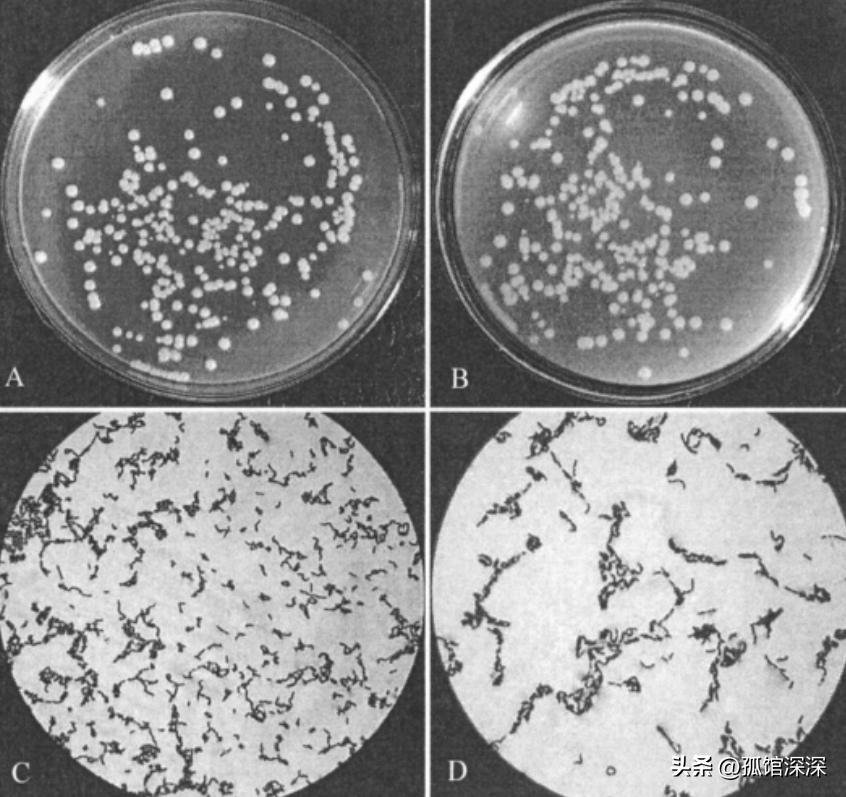
奇异性变形杆菌,奇异变形杆菌内源性感染

文|孤馆深深
编辑|孤馆深深
前言
奇异变形杆菌(PMI)其在琼脂平板上具备群集迁移运动的特点受研究者的广泛关注,它是一种条件致病菌, 能够引起人伤口、眼睛、胃肠道和尿路的感染,是引起导管相关性尿路感染(CAUTI)的主要原因。
细菌毒力
钼是大多数生命体必需的微量元素,由modABC基因编码ModABC蛋白协助细菌以高亲和力转运微量元素钼酸盐,转运至菌体内的钼酸盐以钼辅因子的形式参与钼酶的合成,在细菌的厌氧呼吸中发挥至关重要的作用。
近年来越来越多的研究显示modABC基因与细菌毒力和致病性存在相关性 ,表明它们可能是未来重要的药物靶标,研究发现modABC基因增强肺炎克雷伯菌致肌肉感染,铜绿假单胞菌和结核分枝杆菌的modA基因与细菌生物被膜形成及毒力存在正相关性,提示modABC基因与细菌毒力紧密相关。

目前国内外关于modABC基因在奇异变形杆菌生长代谢过程中的具体功能仍然未知,该基因对奇异变形杆菌毒力因子的作用及致病机制仍待研究, 了解并深入探寻modABC基因在奇异变形杆菌生长、代谢等过程中执行的功能及其毒力基础和致病机制非常必要。
本研究利用自杀载体系统,采用同源重组的方法构建奇异变形杆菌亲本株PMI的modABC基因敲除突变株, 初步研究其生物学特性,通过电感耦合等离子质谱法(ICP-MS)测定其胞内钼含量,并检测其生长曲线,为进一步研究modABC基因的生物学功能及奇异变形致杆菌病性提供参考依据。

modABC基因两侧同源序列及Kn抗性基因的扩增
从NCBI核酸序列数据库获取PMI的基因及其两侧DNA序列,设计合成两侧序列扩增引物-AF、-AR及-BF、-BR,以PMI基因组DNA为模板,分别通过PCR扩增基因上游的*片A**段和下游的B片段,设计合成Kn抗性基因(卡那霉素抗性基因)扩增引物-KnF和-KnR,利用高保真PCR反应从pET28a质粒上扩增Kn抗性基因序列, PCR产物经琼脂糖凝胶电泳鉴定条带正确后,利用胶回收试剂盒纯化后备用,引物序列详见表 1,PCR扩增体系及条件。

同源重组质粒的构建
将质粒pCVD442经SmaI.酶切后割胶纯化,30 °C反应2 h,酶切反应结束后,载体和融合PCR产物分别经1%琼脂糖电泳分离,柱离心纯化,洗脱于50 μL去离子水,经SmaI.酶切后的pCVD442质粒和融合PCR产物与T4 DNA连接酶16 °C反应过夜,连接产物经异丙醇沉淀后,70%乙醇洗涤,溶解于5 μL去离子水。

通过电转化方法将其转入大肠杆菌DH5αλpir,在LB平板(含氨苄青霉素50 μg/mL,卡那霉素25 μg/mL)上于37 °C培养至单克隆形成, 在氨苄青霉素、卡那霉素双抗性平板上生长的克隆含有打靶片段,选择1个克隆测序验证序列正确后进行后续实验,命名为pCVD442-ΔmodABC: : Kn,接种此克隆入3 mL LB(含氨苄青霉素50 μg/mL,卡那霉素25 μg/mL),37 °C培养过夜。

次日柱离心法化纯质粒DNA,将打靶载体pCVD442-ΔmodABC: : Kn电转化进入大肠杆菌β2155菌株,铺LB平板(含氨苄青霉素100 μg/mL,0.5 mmol/L DAP(二氨基庚二酸,阿拉丁试剂), 37 °C培养至单克隆形成,此克隆即为用于接合实验的供体菌株β2155/pCVD442-ΔmodABC: : Kn。

接合实验及modABC基因敲除菌株筛选
在LB平板上划线接种受体菌奇异变形杆菌PMI,37 °C培养至单克隆形成,挑单克隆入3 mL LB,37 °C,220 r/min培养过夜,挑β2155/pCVD442-ΔmodABC: : Kn单克隆入3 mL LB(含Amp 100 μg/mL,0.5 mmol/L DAP),37 °C,220 r/min培养过夜。
取500 μL供体菌β2155/pCVD442-ΔmodABC: : Kn菌液与500 μL受体菌(奇异变形杆菌)菌液混合进行结合实验, 取50 μL接合后菌液涂布于含有氨苄青霉素(100 μg/mL)和卡那霉素(33 μg/mL)的LB平板,30 °C培养至单克隆形成。

在抗性平板上,随机挑选10个克隆,依次用牙签挑入同一管100 μL LB培养基,混合均匀后,取10 μL接种3 mL LB培养基,于30 °C、220 r/min培养过夜,次日,取50 μL培养液铺于含10%蔗糖的LB平板(含Kn 33 μg/mL,不含NaCl),置30 °C培养至单克隆形成,随机挑选14个单克隆,分别接种3 mL LB培养基(含Kn 33 μg/mL),30 °C培养过夜。
次日,取少量菌液用modABC基因内部引物进行PCR鉴定,并用外侧引物进行进一步的鉴定,取内部引物成功鉴定的其中一个克隆的少量菌液, 用外侧引物进行PCR反应,PCR反应体系及条件。

ICP-MS检测钼离子浓度
方法参考GB 5009.268-2016,将冻存的亲本株PMI和敲除株△modABC分别以1[ratio]100比例接种到新鲜的LB培养液中,至于恒温摇床中37 °C振荡培养至稳定期,从中取出1 mL菌液离心,无菌1×PBS清洗两遍,用1 mL无菌1×PBS重悬用接种环取一环细菌四区划线接种至血琼脂平板培养基,37 °C过夜培养。

轻轻刮取血凝脂平板培养基表面的细菌,称取细菌样品0.2~0.5 g(必要时经高速粉碎机粉碎均匀, 精确至0.001 g)于微波消解内罐中,加入5~10 mL硝酸,加盖放置1 h或过夜,旋紧罐盖,按照微波消解仪标准操作步骤进行消解,冷却后取出, 缓慢打开罐盖排气,用少量水冲洗内盖,将消解罐放在控温电热板上或超声水浴箱中。

于100 °C加热30 min或超声脱气2~5 min,添加水定容至25或50 mL,混匀备用,同时做空白试验,按照电感耦合等离子体质谱仪标准操作步骤进行,在调谐仪器达到测定要求后,编辑测定方法,根据待测钼元素的性质选择内标元素103Rh/115In,待测元素和内标元素的m/z为95。
将混合标准溶液注入电感耦合等离子体质谱仪中,测定待测元素和内标元素的信号响应值,以待测元素的浓度为横坐标,待测元素与所选内标元素响应信号值的比值为纵坐标,绘制标准曲线, 将空白溶液和试样溶液分别注入电感耦合等离子体质谱仪中,测定待测元素和内标元素的信号响应值,根据标准曲线得到消解液中待测元素的浓度。


亲本株、缺失株体外培养生长曲线的测定
将冻存的亲本株PMI和敲除株△modABC分别以1 100的比例接种至5 mL LB液体培养基中,37 °C振荡培养过夜后,从中取出1 mL菌液[ratio]12 000 r/min离心2 min, 无菌1× PBS清洗2遍。
用1 mL无菌1×PBS重悬,调整菌液A600 nm值一致至约0.6,再取重悬菌液以1[ratio]100的比例分别接种至LB液体培养基,以此为起始测试点,用PBS调零,每隔2 h测其A600 nm值,重复测量3次,并取均数值绘出生长曲线图。

厌氧生长操作如上,由于尿路感染环境中存在硝酸盐,同时钼酶参与奇异变形杆菌厌氧硝酸盐还原,将NO3-还原为NO2-,对细菌的厌氧生长至关重要,且在硝酸盐存在的情况下奇异变形杆菌仅表达钼酶中的硝酸还原酶。
而在硝酸盐不存在的情况下奇异变形杆菌除钼酶外还表达延胡索酸酶,因此在培养基中考虑添加硝酸盐进行实验, 将重悬菌液分别接种至添加20 mmol/L和不添加20 mmol/L硝酸钾的LB液体培养基,置于厌氧罐密封培养,每隔3 h测定。

钼酸盐转运蛋白ModABC由modABC编码, 是细菌内负责转运钼酸盐合成钼酶的主要转运蛋白,奇异变形杆菌利用钼酶中的硝酸盐还原酶还原尿中硝酸盐为亚硝酸盐,作为呼吸酶系统的终末受氢体,尿路的混合感染增加了细菌对厌氧硝酸还原酶系统的需求。

多项研究证实,modABC基因与细菌毒力及致病性相关,研究发现敲除modA基因后,铜绿假单胞菌钼酸盐浓度下降, 导致在硝酸盐含量减少及在缺氧环境下生长受限 ,并引起铜绿假单胞菌菌膜形成能力以及脂肪酸构成发生改变。
肺炎克雷伯菌的全局调控因子与modABC基因表达存在相关性,与细菌毒力相关,并通过ModABC转运蛋白在宿主体内转运钼酸盐进行厌氧硝酸盐呼吸,产生适应性优势,增强侵袭性,促进肌肉感染[11],钨酸盐作为钼的竞争性*制剂抑**消除厌氧呼吸所赋予的适应性优势。

modA转座子插入突变体削弱了小鼠肺部的增殖和毒力,Mo的转运与结核分枝杆菌毒力也存在相关性,目前国内外对modABC在奇异变形杆菌致病中的作用尚无任何报道,对modABC与奇异变形杆菌毒力及致病性的研究显得尤为重要,构建突变株是研究细菌相关致病基因功能的重要途径和方法, 利用基因敲除对探究奇异变形杆菌的modABC基因在致病过程中的功能至关重要。

用于研究微生物基因功能的同源重组基因敲除的方法包括自杀载体同源重组和Red同源重组等,彭亮等提出相比于用λRed同源重组技术进行PMI的基因敲除,自杀载体系统的一次重组效率高,可进行框内缺失突变实现单纯的基因阅读框内碱基序列的缺失,且可避免极性效应的产生。

国内外已有许多基于自杀载体同源重组的基因敲除技术的报道,因此本研究采用基于自杀载体的同源重组法构建modABC基因缺失突变株,通过同源重组技术,利用含反向筛选基因sacB(蔗糖致死基因)的pCVD442质粒构建modABC的缺失突变株。
主要分2步,当含有同源臂的自杀载体导入目的菌株时,在生存压力下发生第一轮单交换,自杀载体与染色体DNA发生同源重组, 而后在反向筛选的压力下发生第二轮的单交换消除质粒,以在蔗糖平板上生长,最终将基因敲除。

成功构建奇异变形杆菌modABC基因敲除株以研究其在菌株摄取钼酸盐、体外有氧及厌氧环境下培养的生长能力的改变,重组效率高,有效避免了对上下游基因造成的潜在极性效应。
结论
与自杀载体的同源重组可用于 奇异变形杆菌 中的 modABC 基因敲除, modABC 基因参与钼酸盐的摄取,并与奇异变形杆菌在硝酸盐存在下的厌氧生长有关。
参考文献
1.张 利锋, 李 娟, 卢 金星. 奇异变形杆菌耐药性研究进展 疾病监测 2016;31(5):427–32.
2. 彭 亮, 黄 瑞娇, 肖 柯玲, et al. 2011—2013年奇异变形杆菌临床分离株的耐药性分析 热带医学杂志 2014;14(7):853–5.
3.佩德里克 VG, 艾克尔坎普 BA, 维恩 MP, 等. 钼酸盐在铜绿假单胞菌中的获得和作用.应用环境微生物, 2014;80(21):6843–52。
4.王 慧, 卢 慧改, 徐丽, 等. 钼酸盐转运体ModABC促进肺炎克雷伯菌肌肉感染及其治疗新思路 微生物学通报 2021;48(8):2784–800。
5. 张 佩, 梁 爱华, 王丹, 等. GB 5009.268-2016食品中钠、铅测定的方法验证 2017;44(23):4256–62。